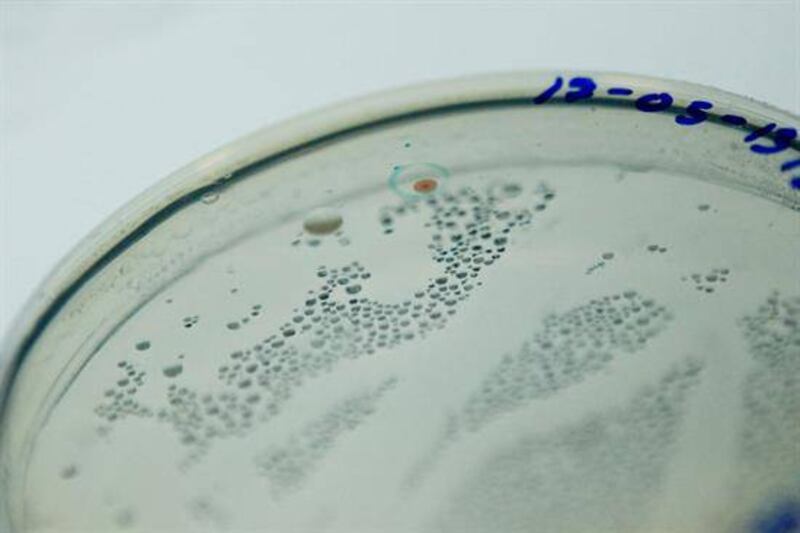

Estados Unidos ha detectado el primer caso de “superbacteria” resistente a los antibióticos de último recurso en su territorio, una temida cepa de la bacteria “Escherichia coli” que se encontró por primera vez en China el pasado noviembre.
Investigadores de Defensa detectaron la bacteria en la orina de una mujer de 49 años de Pensilvania vinculada al departamento y que no había salido del país en los últimos cinco meses, según informaron hoy las autoridades de salud de EEUU en varias entrevistas.

La cepa de esta bacteria contiene uno de los genes móviles que confiere resistencia a la colistina, el antibiótico que las autoridades de salud usan como último recurso en los casos de las bacterias más difíciles de combatir.
“Básicamente (este descubrimiento) nos muestra que el final del camino no está muy lejos para los antibióticos, que quizás estemos en una situación donde tendremos pacientes en las unidades de emergencia o pacientes con infecciones urinarias para los que no tenemos antibióticos”, dijo el director de los Centros de Prevención y Control de Enfermedades (CDC), Tom Frieden en una entrevista con el Washington Post.
Este descubrimiento “anuncia la emergencia de una bacteria verdaderamente resistente a todas las medicinas”, escriben los investigadores de defensa en un estudio sobre el hallazgo publicado ayer en la revista especializada “Antimicrobial Agents and Chemotherapy”.

La existencia del “gen mcr-1”, la razón por la que esta bacteria es temible, se encontró por primera vez el pasado noviembre, cuando un estudio de científicos británicos y chinos reveló su detección en un pequeño grupo de personas, carne y animales en China.
“Dado que las bacterias pueden propagar estos genes entre ellas, se activa una situación en la que podemos ver bacterias resistentes a todos los antibióticos conocidos. Y eso, por supuesto, es una perspectiva aterradora para todos nosotros”, dijo a la PBS Beth Bell, del Centro de Control y Prevención de Enfermedades (CDC).
Por ejemplo, si la “enterobacteria resistente a los carbapenemes (ERC)”, considerada una “bacteria pesadilla” por los científicos, adquiriera resistencia a la colistina, sería imposible de combatir.
Esa bacteria mata a unas 600 personas al año en Estados Unidos y en 2015 se detectó en 44 instalaciones médicas del país.
“Como las bacterias se reproducen tan rápidamente, a veces hay mutaciones que permiten que cierta cepa supere a los antibióticos y adquiera resistencia a ellos”, explicó Bell, directora de enfermedades infecciones emergentes en los CDC.
“Esto, por supuesto, subraya la importancia de usar antibióticos solo en el momento correcto y con la dosis correcta, porque el sobreuso de antibióticos, por supuesto, puede espolear que las bacterias desarrollen ese tipo de mecanismos de resistencia”, añadió la experta.
Según Friedman, “estamos en riesgo de un mundo post-antibiótico” y este escenario “no solo afectaría a pacientes con infecciones del trato urinario o neumonía, sino también a los 600.000 pacientes que cada año necesitan tratamiento contra el cáncer”.
